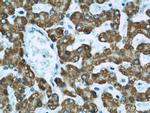
ECHS1 Antibody in Immunohistochemistry (Paraffin) (IHC (P))

Search
Proteintech
ECHS1 Polyclonal Antibody
{{$productOrderCtrl.translations['antibody.pdp.commerceCard.promotion.promotions']}}
{{$productOrderCtrl.translations['antibody.pdp.commerceCard.promotion.viewpromo']}}
{{$productOrderCtrl.translations['antibody.pdp.commerceCard.promotion.promocode']}}: {{promo.promoCode}} {{promo.promoTitle}} {{promo.promoDescription}}. {{$productOrderCtrl.translations['antibody.pdp.commerceCard.promotion.learnmore']}}
产品信息
11305-1-AP
种属反应
已发表种属
宿主/亚型
分类
类型
抗原
偶联物
形式
浓度
规格
纯化类型
保存液
内含物
保存条件
运输条件
产品详细信息
Immunogen sequence: MAALRVLLS CVRGPLRPPV RCPAWRPFAS GANFEYIIAE KRGKNNTVGL IQLNRPKALN ALCDGLIDEL NQALKIFEED PAVGAIVLTG GDKAFAAGAD IKEMQNLSFQ DCYSSKFLKH WDHLTQVKKP VIAAVNGYAF GGGCELAMMC DIIYAGEKAQ FAQPEILIGT IPGAGGTQRL TRAVGKSLAM EMVLTGDRIS AQDAKQAGLV SKICPVETLV EEAIQCAEKI ASNSKIVVAM AKESVNAAFE MTLTEGSKLE KKLFYSTFAT DDRKEGMTAF VEKRKANFKD Q (1-290 aa encoded by BC008906)
靶标信息
The protein encoded by this gene functions in the second step of the mitochondrial fatty acid beta-oxidation pathway. It catalyzes the hydration of 2-trans-enoyl-coenzyme A (CoA) intermediates to L-3-hydroxyacyl-CoAs. The gene product is a member of the hydratase/isomerase superfamily. It localizes to the mitochondrial matrix. Transcript variants utilizing alternative transcription initiation sites have been described in the literature.
仅用于科研。不用于诊断过程。未经明确授权不得转售。
生物信息学
蛋白别名: ECHS1; enoyl Coenzyme A hydratase, short chain 1; enoyl Coenzyme A hydratase, short chain, 1, mitochondrial; Enoyl-CoA hydratase 1; Enoyl-CoA hydratase short chain 1 mitochondrial; Enoyl-CoA hydratase, mitochondrial; Enoyl-CoA hydratase, short chain 1, mitochondrial; enoyl-CoA hydratase, short chain, 1, mitochondrial; epididymis secretory sperm binding protein; mECH; mitochondrial short-chain enoyl-coenzyme A hydratase 1; SCEH; short chain enoyl-CoA hydratase; Short-chain enoyl-CoA hydratase
基因别名: C80529; ECHS1; ECHS1D; mECH; mECH1; SCEH
UniProt ID: (Human) P30084, (Rat) P14604, (Mouse) Q8BH95
Entrez Gene ID: (Human) 1892, (Rat) 140547, (Mouse) 93747